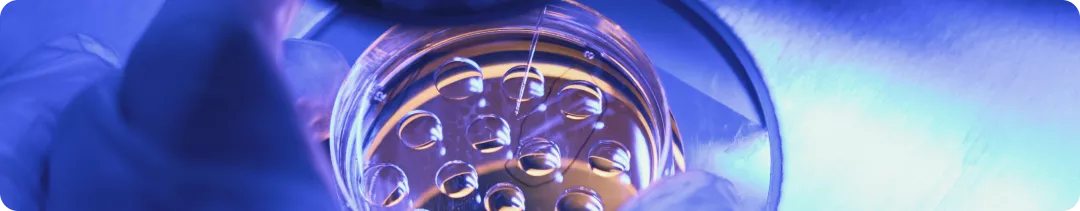
Тонкоигольная биопсия vs трепан-биопсия

Тонкоигольная биопсия vs трепан-биопсия
Биопсия является важнейшим этапом мультимодальной диагностики патологии молочной железы. Это процедура получения биологического материала из выявленного образования молочной железы. Она позволяет провести в дальнейшем цитологический, гистологический, иммуногистохимический и молекулярно-генетический виды диагностики.
Отрицательные или сомнительные результаты комплексного обследования, при сохраняющемся подозрении на злокачественное новообразование (ЗНО), требуют проведения биопсии.
Отсутствие данных, подтверждающих диагноз РМЖ в биоптате, является показанием к динамическому клинико-рентгено-сонографическому контролю через 3–6 месяцев. Если при динамическом наблюдении отмечается рост образования и другие признаки трансформации структуры: изменение степени ее однородности, васкуляризации, коэффициента жесткости, что усиливает подозрения на ЗНО, требуется выполнение повторной биопсии.
Среди способов, позволяющих получить клеточный и тканевой материал из выявленного новообразования молочной железы, в клинической практике чаще всего используются: тонкоигольная аспирационная биопсия (ТАБ), прицельная толстоигольная биопсия системой "пистолет-игла" под рентгенологическим или ультразвуковым контролем, трепан-биопсия.
Подготовка к биопсии образования молочной железы:
- За неделю до процедуры прекратить прием антикоагулянтов и аспирина, так как эти препараты могут усиливать кровоточивость тканей
- За двое суток до процедуры исключить приём алкогольных напитков
- Не планировать биопсию на время менструации у пациентки
- При необходимости проведения общей анестезии в день, предшествующей дате выполнения вмешательства, рекомендовать пациентке отказаться от ужина
- Пациент обязан сообщить врачу обо всех принимаемых им препаратах, витаминах и пищевых добавках, о возможных аллергических реакциях, беременности, наличии кардиостимулятора
- В день проведения процедуры пациенту необходимо воздержаться от использования дезодорантов, косметических лосьонов и других средств, которые наносятся на кожу подмышечной впадины
- Пациент должен отказаться от курения в день проведения биопсии.
- Рекомендуйте пациентке в день проведения процедуры надеть бюстгальтер для достижения возможности краткосрочного удержания пузыря со льдом на месте прокола
Тонкоигольная аспирационная биопсия (ТАБ)
Трепан-биопсия молочной железы (ТБ)
Стереотаксическая пункционная биопсия (СТБ)
Показания для СТБ молочной железы:
- отрицательный ответ, полученный при традиционной ТБ, при сохраняющихся аргументированных подозрениях на РМЖ
- отёчные формы рака молочной железы, не позволяющие чётко локализовать зону интереса
- «глубокое» расположение опухолевого узла
- не пальпируемые узловые образования МЖ с признаками злокачественности (BI -RADS 4 -5), такими как нечеткие или тяжистые контуры, неоднородная структура за счет кальцинатов злокачественного типа, рост образования в динамике
- сгруппированные микрокальцинаты без видимого узлового образования (BI -RADS 4 -5)
- тяжистая перестройка структуры локального характера с вкраплениями микрокальцинатов или без них (BI -RADS 4 -5)
- в зависимости от клинического подозрения и предпочтения пациента поражение, классифицируемое как категория 3 по BI -RADS и визуализируемое только при маммографии, также может быть направлено на трепан-биопсию
Правильно взятый образец тканей тонет в 10% растворе нейтрального формалина. Если получена жировая ткань, а не опухоль – столбик тканей плавает на поверхности.
Список литературы
- Вопросы маммологии. Под редакцией академика РАН А.Д. Каприна. Библиотека врача-онколога. Обнинск-Москва, 2020.
- Клинические рекомендации МЗ РФ "Рак молочной железы", 2021
- Бусько Е.А. Мультипараметрическое ультразвуковое исследование в ранней диагностике и мониторинге лечения рака молочной железы. Диссертация на соискание ученой степени доктора медицинских наук. Санкт-Петербург, 2021.
- Тюляндин С.А., Жукова Л.Г., Королева И.А., Пароконная А.А., Семиглазова Т.Ю., Стенина М.Б. и соавт. Практические рекомендации по лекарственному лечению рака молочной железы. Злокачественные опухоли : Практические рекомендации RUSSCO #3s2, 2021 (том 11). 09
- Чёрная А. В., Ульянова Р. Х., Шевкунов Л. Н., Багненко С. С., Криворотько П. В., Рогачев М. В., Новиков С. Н., Дышлюк Т. Л., Брезгина Е. А., Шевченко Е. Ю., Жильцова Е. К., Зайцев А. Н., Артемьева А. С., Лобода Ю. В. Стереотаксическая биопсия образований молочной железы под рентгеновским контролем: учебное пособие для обучающихся в системе высшего и дополнительного профессионального образования. – Санкт -Петербург:НМИЦ онкологии им. Н.Н. Петрова, 2021. – 76 с.
- Agarwal I., Blanco L. WHO classification. PathologyOutlines.com website. http://www.pathologyoutlines.com/topic/breastmalignantwhoclassification.....
- Bevers T.B. et al. Breast cancer screening and diagnosis, version 3.2018, NCCN clinical practice guidelines in oncology //Journal of the National Comprehensive Cancer Network. – 2018. – T. 16. – N. 11. – С. 1362-1389.
- Wang M. et al. A sensitivity and specificity comparison of fine needle aspiration cytology and core needle biopsy in evaluation of suspicious breast lesions: A systematic review and meta-analysis. Breast Edinb Scotl 2017;31:157–166.
- Barco I. et al. Role of axillary ultrasound, magnetic resonance imaging, and ultrasound-guided fine-needle aspiration biopsy in the preoperative triage of breast cancer patients. Clin Transl Oncol Off Publ Fed Span Oncol Soc Natl Cancer Inst Mex 2017;19(6):704–710.
- Provenzano, E. Molecular Classification of Breast Cancer / E. Provenzano, G. A. Ulaner, S.-F. Chin // Pet Clinics. ‒ 2018. ‒ Vol. 13, № 3. ‒ P. 325-338.
- Lebeau, A. Invasive breast cancer: the current WHO classification /A. Lebeau., M. Kriegsmann, E. Burandt, H. P. Sinn // Pathologe. ‒ 2014. ‒ Vol. 35, № 1. ‒ P. 7-17
- Chamming's, F. Imaging features and conspicuity of invasive lobular carcinomas on digital breast tomosynthesis / F. Chamming's, E. Kao, A. Aldis, R. Ferre, A. Omeroglu, C. Reinhold, B. Mesurolle // British Journal of Radiology. ‒ 2017. ‒ Vol. 90, № 1073. С. 20170128.
- Koh, V. C. Y. Behaviour and characteristics of low-grade ductal carcinoma in situ of the breast: literature review and single centre retrospective series / V. C. Y. Koh, J. C. T. Lim, A. A. Thike, P. Y. Cheok, M. M. M. Thu, H. Li, V. K. M. Tan, K. W. Ong, B. K. T. Tan, G. H. Ho, S. Thilagaratnam, J. S. L. Wong, F. Y. Wong, I. O. Ellis, P. H. Tan // Histopathology. ‒ 2019. – Vol. 74 (7). – P. 970-987.
11328228/RIB/web/12.24/0



